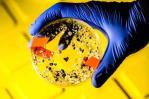
Los microplásticos reducen el carbono que el océano arrastra al fondo

La crisis climática amenaza la vida de 41 millones de personas en Latinoamérica, según ONU
Crisis climática pone en peligro vida y salud en zonas costeras de baja altitud

La crisis climática amenaza los medios de vida y la atención sanitaria de 41 millones de personas en zonas costeras de baja altitud en Latinoamérica y el Caribe, según un nuevo estudio del Fondo de Población de las Naciones Unidas (UNFPA, en inglés) publicado este martes.
El informe, para el que se han usado imágenes por satélite, datos geoespaciales y estimaciones de población, establece que estas bajas comunidades litorales de la región están más expuestas a riesgos como la sequía, la desertificación, huracanes o tormentas.
"Los fenómenos meteorológicos extremos suelen traer como consecuencia inundaciones generalizadas que destruyen hogares, empresas y servicios esenciales, además de la atención sanitaria", añade el documento.
Los datos se presentaron en la cuarta Conferencia de Pequeños Estados Insulares en Desarrollo (PEID4), que se celebra en Antigua y Barbuda hasta el jueves, donde UNFPA está pidiendo principalmente a los países participantes mayores inversiones para reducir las desigualdades de su población y una mejor gestión de los recursos hídricos.
Mujeres y niñas, las más afectadas
De acuerdo a esta agencia de la ONU especializada en política demográfica, la población más afectada por estas condiciones son mujeres y niñas que, "fruto de las desigualdades", sufren "de forma desproporcionada" la falta de acceso a partos seguros o protección frente a la violencia de género.
"Millones de mujeres y niñas vulnerables, que son las menos responsables de la crisis climática, pagan un alto precio cuando se producen catástrofes relacionadas con el clima y se alteran los servicios básicos de salud y protección, así como los medios de subsistencia", declaró la directora ejecutiva de UNFPA, la doctora Natalia Kanem, en el estudio.
El análisis también muestra que 1.448 hospitales vitales para la salud de madres y para la planificación familiar están situados en zonas costeras de baja altitud más propensas a los riesgos naturales.
En territorios como Aruba, Islas Caimán, Surinam, Bahamas y Guyana, más del 80 % de los hospitales se encuentran en estas áreas litorales bajas, mientras que en el resto de América Latina y el Caribe, los países con mayor número de centros médicos en dichas latitudes son Ecuador (11.9 %), Haití (10 %) o Brasil (7.2 %), según UNFPA.
PEID4, que presta especial atención a la "amenaza existencial" de la crisis climática, se celebra antes de que inicie la temporada de huracanes en el Atlántico y podría tener un impacto "brutal" en la región este año, según la organización.

EFE